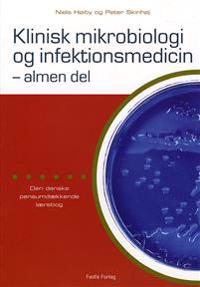
Klinisk mikrobiologi og infektionsmedicin - almen del

Priser hos nätbutiker
| Butik | Mervärde | Pris | Tillgänglighet | Leveranstid | Inkl frakt | Länkar |
|---|---|---|---|---|---|---|
 |
Nordens största bokhandel med över 10 miljoner titlar. Alltid låga priser | 210.00 kr | I lager | 2-5 dagar | 210.00 kr | Till butik |
 |
Alltid störst sortiment Bonustrappa; samla inköp och få unika erbjudanden | 219.00 kr | I lager | 3-6 dagar | 248.00 kr | Till butik |
Obs! Glöm inte att alltid kolla priset hos återförsäljaren!